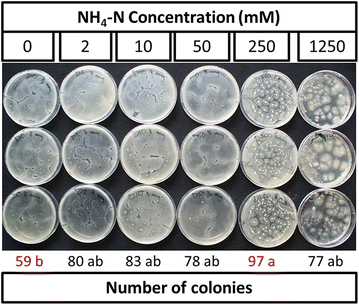
figure 5
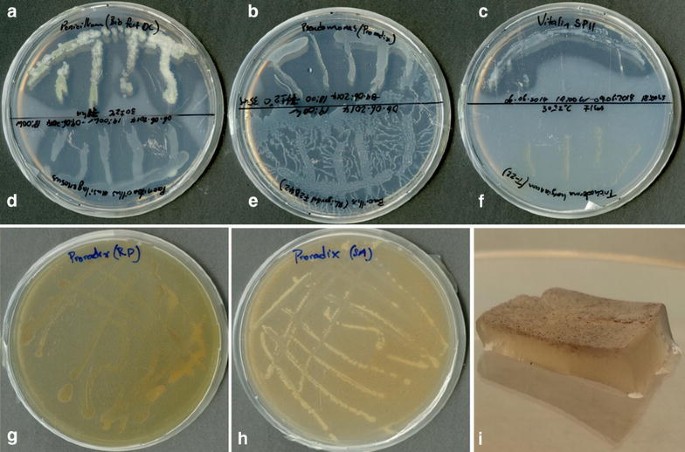
figure 7

- Research
- Open access
- Published:
Densely rooted rhizosphere hotspots induced around subsurface NH4 +-fertilizer depots: a home for soil PGPMs?
Chemical and Biological Technologies in Agriculture volume 4, Article number: 29 (2017)
Abstract
Background
Populations of plant growth-promoting microorganisms (PGPMs) inoculated in natural soil typically decline over time due unfavourable biotic and/or abiotic factor(s). Improving subsurface root density may enhance PGPM establishment due to high concentrations of organic nutrients released as root exudates. Placing subsurface root-attracting NH4 +-fertilizer depots may form such zones of dense localized rooting (“rhizosphere hotspots”) that can enhance PGPM survival. Nevertheless, required soil conditions that favour formation of rhizosphere hotspots are unknown. This study aimed to investigate: (1) background soil N min effect on NH4 +-depot-zone root growth; (2) PGPM tolerance to high NH4 + concentrations (± nitrification inhibitor, DMPP); (3) ability to solubilize sparingly soluble inorganic phosphates; (4) and establishment in a subsurface NH4 +-depot.
Methods
We conducted a greenhouse rhizobox experiment using spring wheat (Triticum aestivum L.) to investigate the effect of background N min (0, 5, 20 and 60 mg N kg−1) on root growth around a 1 g NH4 +–N depot. The tolerance of selected PGPMs to 0, 2, 10, 50, 250, 1250 mM NH4–N and 0, 0.1, 1 and 3 M NH4–N ± DMPP was investigated via in vitro culture tests. Promising candidates were further tested for solubilization of tri-calcium phosphate (Ca–P), rock phosphate (RP) or sewage sludge ash (SA). One PGPM was inoculated in a 15N-labelled (NH4)2SO4 + DMPP depot in rhizobox-grown maize (Zea mays L.) and root colonization was measured.
Results and discussion
N min 5–20 mg N kg−1 improved depot-zone root growth, whereas 60 mg N kg−1 reduced it. Tested PGPMs were tolerant to up to 1250 mM NH4–N. Pseudomonas sp. DSMZ 13134 and B. amyloliquefaciens FZB42 (not Trichoderma harzianum T-22) solubilized Ca–P and RP via acidification, whereas SA was not solubilized despite marked acidification. Placed 15N-labelled (NH4)2SO4 + DMPP depot led to increased localized rooting, rhizosphere acidification, shoot 15N signal, N and P concentrations and contents than homogenously applied Ca(NO3)2. Inoculation of Pseudomonas sp. DSMZ 13134 tended to increase shoot N and P concentrations, and shoot N content relative to the control. Higher colonization of Pseudomonas sp. DSMZ 13134 was measured in soil around the NH4 +-depot than in corresponding soil zone in treatments with NO3 −.
Conclusion
These results show the first promising effects of combining fertilizer placement and application of P-solubilizing PGPMs on plant growth.

Background
Subsurface placement of manures or mineral fertilizers produces higher crop nutrient uptake and yield than conventional surface broadcast [1,2,3,4]. Among others, intense rooting in nutrient patches and increased nutrient uptake rates favour exploitation of subsurface fertilizer depots. Therefore, providing high concentrations of nutrients that stimulate root growth at the site of root contact (e.g. NH4 + and HPO4 2−/H2PO4 − or CO(NH2)2 and HPO4 2−/H2PO4 −, the later under optimal ammonification conditions) [2, 5] and are poorly mobile in soil [6,7,8,9], crops can more efficiently acquire fertilizer-depot nutrients, thus improving their yields [4]. Nevertheless, it has been shown that intense rooting may not occur around fertilizer depots based on manure or mineral N under greenhouse and field conditions [10]; (Müller et al. 2009, unpublished results). The reasons for this are unclear. Therefore, we hypothesize that localized root growth around a subsurface fertilizer depot depends on high nutrient concentration gradients between the depot and background soil. Suggesting that a strong localized root growth response to a subsurface fertilizer depot is more likely when nutrient concentration is high in the depot and/or low in bulk soil than the other way, Sommer [11] proposed N fertilization by subsurface application of high and toxic concentrations of NH4 +, thus creating a strong contrast to bulk soil N concentration. Moreover, NH4 +-toxicity within such depots inhibits microbial nitrification, resulting in more persistent NH4 +-induced root growth intensification. This NH4 +-based N fertilization technique has been termed controlled long-term ammonium nutrition (CULTAN) [11]. Use of stabilized NH4 + (e.g. nitrification inhibitor (NI), 3,4-dimethylpyrazole phosphate (DMPP) [12] will additionally inhibit nitrification around depot boarders where NH4 +-concentrations become less toxic with time.
Nevertheless, for plant species that respond to soil nutrient patches by high turnover rates of roots within the patch (high root birth and death rates e.g. Ambrosia artemisiifolia), a net increase in patch root density may not be observed [13].
Another approach to directly or indirectly improve plant acquisition of applied or soil nutrients is to inoculate soil with plant growth-promoting microorganisms (PGPMs) e.g. P-solubilizing bacteria and fungi. PGPMs have been described to promote plant growth via one or a combination of mechanisms. Pseudomonas sp., Bacillus sp. or Xanthomonas sp. have been shown to produce the phytohormone indole acetic acid (IAA) to promote plant root growth and/or the enzyme ACC-deaminase (1-aminocyclopropane-1-carboxylate deaminase), which delays root senescence by reducing ethylene levels under stress conditions [14,15,16,17]. These PGPMs have also been shown to synthesize various antifungal metabolites (e.g. phenols and phenazines) that directly suppress root pathogenic fungi and also function as low-molecular weight iron-complexing ligands (e.g. siderophore pyoverdine) for effective competition against root pathogens for iron and other nutrients [18, 19]. Other species of Bacillus, Pseudomonas, Enterobacter and Trichoderma have been shown to release protons, organic acids and chelating metabolites (e.g. Oxalic, fumaric, citric, dl-malic, dl-lactic and succinic acids) that enhance the solubility of sparingly soluble phosphates and/or secrete enzymes like phosphatases and phytases that mineralize organic phosphates in soil making them plant-available [20,21,22,23,24,25].
In order that applied PGPMs improve plant nutrient acquisition from subsurface NH4 +-based fertilizer depots, they must be considerably tolerant to extreme pH, high NH4 + and salt concentrations found within and around such depots. For depots with stabilized N, tolerance to nitrification and/or urease inhibitors is additionally required for PGPM survival and root colonization within the developing “rhizosphere hotspot”.
The overall aim of this study was to employ fertilizer placement as a tool to induce dense localized rooting in soil (“rhizosphere hotspot”) for improved establishment of selected soil-inoculated PGPMs thereby enhancing plant nutrient-acquisition and biomass production. Rhizosphere hotspots are proposed to be areas that favour PGPM establishment in soil due to the presence of high concentrations of organic nutrients released as root exudates. We made the following hypotheses: (1) formation of rhizosphere hotspots around NH4 +-depots is inhibited by high background mineral N concentration (N min) and promoted by low bulk soil N min. (2) Certain PGPMs (also referred to as microbial bio-effectors, BEs) tolerate high concentrations of NH4 + (± DMPP) that are well above the limits for NH4 +-tolerant crop species like rice (Oryza sativa L.). (3) BEs are able to solubilize different sparingly soluble mineral phosphates (including recycled P fertilizers) in solid and liquid in vitro cultures. (4) Inoculation of a P-solubilizing BE around a subsurface stabilized (DMPP) concentrated 15N-labelled NH4 + depot improves BE establishment and increases N and P uptake in maize (Zea mays L.).
Materials and methodology
Effect of background N min on NH4 +-depot root growth
We cultivated spring wheat (Triticum aestivum L. var Schirocco, KWS, 1197, 29296 Bergen, Germany) in PVC rhizoboxes (40 × 20 × 2 cm, H × W × D). The Substrate was composed of 80% C-horizon loess (P CAL, 5 mg kg−1; P total, 332 mg kg−1; pH (CaCl2), 7.6; C org, < 0.3%; N total 0.02%) and 20% quartz sand (0.6–1.2 mm Ø) (w/w). Basic fertilization included (kg−1 dry soil DM): 150 mg P (Ca(H2PO4)2), 200 mg K (K2SO4), 100 mg Mg (MgSO4), 20 μmol Fe-EDDHA (Sequestrene 138, 6% Fe), 2.6 g Zn (ZnSO4); 1 mg Cu (CuSO4); 2.2 mg Mn (MnSO4), 0.54 mg Mo (Na2MoO4) and 0.86 mg B (H3BO3). Moisture content was set to 26% (60–70% max. WHC). Treatments included increasing bulk soil N min concentrations: 0, 5, 20 and 60 mg N kg−1 soil DM (NH4NO3). A stabilized NH4 +-depot was placed 7 cm to the side and 16 cm below two wheat seedlings in each rhizobox. The NH4 + depot (1.0 g NH4–N + 0.17 g NO3–N + 0.01 g DMPP) was made by placing 3.49 g (NH4)2SO4 in soil over which 2.5 mL solution of 1.1 M NH4NO3 containing DMPP(4 g L−1) was pipetted. The depot was mixed in a small soil volume of 5 cm3 (2.5 cm Ø × 2 cm depth) resulting in a high NH4–N concentration within the depot of 78.4 mg g−1 soil (bulk density, 1.3 g cm−3). DMPP was added at the recommended rate of 1% NH4–N (w/w) [12]. Each rhizobox contained 2.6 kg substrate.
Before transplanting, seed surfaces were disinfected by soaking in 3% H2O2 for 10 min. Afterwards seeds were soaked for 10 h in 2.5 mM CaSO4 and pre-germinated on filter papers that were also soaked in 2.5 mM CaSO4 (48 h at 25 °C in darkness). Two healthy seedlings (distinct shoot and root length ≥ 2 cm) were transplanted to each rhizobox. Greenhouse conditions were as follows: day/night length: 8 h/16 h, daytime light intensity: 311 µmol m−2 s−1 (ALMEMO 239-3, AHLBORN), av. daily temperature 15 °C (8–21 °C) and av. daily relative humidity 42% (30–65%) (Voltcraft, DL-141 TH). Four replicates were made per treatment and were arranged in a completely randomized design. Plants were grown for 60 days (10 February–07 April 2013). Total root length visible through the root observation window of the rhizobox in the radial zones: 0–4, 4–8 and > 8 cm from the NH4 +-depot was measured at 12, 36 and 56 days after planting. Using a fine black water-resistant marker, roots were drawn on a polyethylene sheet (40 × 20 cm) placed over the soil surface on the rhizobox window. Drawings were scanned (Epson Expression 10000 XL) and analysed for total root length using WinRhizo Pro V. 2009c (Regent Instruments Inc., Canada). At the end of the growth period, root length density (cm cm−3 of substrate) could not be appropriately measured because, as shown in Fig. 2, roots grew into the nylon sheet lining the rear of the rhizobox, making it impossible to satisfactorily harvest roots. After harvesting, shoot dry weight was measured, depot and bulk soil samples were collected and frozen for later analysis of NH4–N and NO3–N concentrations.
PGPM tolerance to high NH4 +-concentrations
The PGPMs shown in Table 1 were grown on appropriate solid nutrient media with increasing concentrations of NH4–N. For each medium, six solutions with the following NH4 + concentrations were prepared using deionized water: 0, 2, 10, 50, 250 and 1250 mM NH4–N ((NH4)2SO4). For each NH4 +-level, the constituents per liter of medium were dissolved in the corresponding solution to a final volume of 1000 mL. The pH was then adjusted to the desired level using 1 N NaOH or HCl and finally, the medium was sterilized by autoclaving at 121 °C for 20 min.
The following solid media were prepared for each NH4 +-level:
(1) Nutrient agar (5.0 g peptone; 3.0 g meat extract; 15.0 g agar; pH 7); (2) King’s B medium (from ready-made preparation [King’s B medium (Basis), Carl Roth GmbH + Co. KG]; 38 g medium and 10 mL glycerol in 990 ml deionized water; pH 7); (3) DEV medium (Deutsche Einheitsverfahren; 10.0 g peptone; 10.0 g meat extract; 5.0 g NaCl; 18.0 g agar; pH 7.2); and (4) malt extract peptone agar (30.0 g malt extract; 3.0 g soya peptone; 15.0 g agar; pH 5.6).
At 45 °C, about 20 mL of each medium was poured into a sterile petri dish. For bacterial PGPMs, inocula were prepared as diluted suspensions in 2.5 mM CaSO4. For each bacterium and NH4 +-level, 100 µL inoculum (about 50 CFUs) was pipetted onto a petri dish and evenly spread using a Drigalski spatula. For each fungus, a small fragment of pre-cultured mycelium was placed at the centre of the petri dish. There were three replicates per treatment randomly placed on the same incubator shelf (incubator: WBT, Binder, Typ 1711509900313, Tuttlingen, Germany) and cultured at 24 ± 1 °C under aerobic conditions in darkness. Trichoderma harzianum strains were grown for 48 h and the remaining PGPMs for 1 week.
An additional incubation test on normal NH4 +-free agar was performed. For this, selected BEs suspended in high concentrations of NH4–N ((NH4)2SO4 ± DMPP) were pre-incubated at 25 ± 2 °C for 15 min or 24 h before inoculation on NH4 +-free agar. This modification was meant to simulate addition of BEs directly into a concentrated NH4 +-fertilizer solution ((NH4)2SO4 ± DMPP) before placement in soil. The aim was to investigate BE viability directly after exposure to high NH4–N ± DMPP levels. Pseudomonas sp. DSMZ 13134, Bacillus amyloliquefaciens FZB42 and Trichoderma harzianum T-22 were tested. After pre-incubation for 15 min, 100 µL of each bacterial inoculum suspension in 0, 0.1, 1 or 3 M (NH4)2SO4 ± DMPP (about 50 CFUs) was inoculated on culture media and incubated at 25 ± 2 °C for 48 h. in darkness under aerobic conditions. For T. harzianum T-22, 100 µL 0, 0.1, 1 or 3 M (NH4)2SO4 ± DMPP was pipetted on a fragment of pre-cultured mycelium and after 15 min, the mycelium fragment was placed on NH4 +-free agar. This procedure was adopted for T. harzianum T-22 because the effect of (NH4)2SO4 ± DMPP on its survival and growth could be best quantitatively analysed by measuring the diameter of intact pieces of growing mycelium. There were four randomly placed replicates per treatment. For 24 h BE pre-incubation, only 1 or 3 M (NH4)2SO4 ± DMPP solutions were used because marked NH4 +-tolerance was observed at 15 min. pre-incubation. There were only three replicates per treatment to reduce bulk and facilitate management of the experiments. For 24 h. pre-incubation, T. harzianum T-22 spores were used as inoculum instead of a fragment of pre-cultured mycelium to be more relevant to field application. Therefore, only the presence or absence of a growing T. harzianum T-22 mycelium could be recorded. Growth could not be quantified because of the absence of a distinct circular mycelium to measure the diameter. For bacteria, colony characteristics were recorded and for Pseudomonas sp. DSMZ 13134, colonies were observed under UV light for typical yellow-green fluorescence.
Solubilization of inorganic phosphates by PGPMs
Solid media culture
To investigate the ability of selected PGPMs to solubilize insoluble inorganic phosphates, Deubel-Muromcev solid agar containing a suspended precipitate of tri-calcium phosphate (Ca3(PO4)2) (Ca–P) was prepared [26, 27]. 0.2 g K2SO4, 0.4 g MgSO4·7H2O, 20 g Purified agar (Oxoid, No. LP 0028) were dissolved to a total volume of 1000 mL using deionized water. The pH of the solution was adjusted to 6.9 using 1 N NaOH or HCl and then it was autoclaved (121 °C, 20 min). After cooling the solution to 60 °C, 10 g D (+) Glucose monohydrate (6887.1, Roth, Karlsruhe, Germany) dissolved in 110 mL deionized water and 1 g l-asparagine monohydrate (11160, Fluka, Buchs, Germany) dissolved in 50 ml deionized water were added (Solution A). To precipitate non-soluble Ca–P in the medium, 2.2 g CaCl2·2H2O (2461.1000 Chem Solute Th.Geyer, Renningen, Germany) dissolved in 20 mL deionized water and 3.8 g Na3PO4·12H2O (6578, E. Merck, Darmstadt, Germany) also dissolved in 20 ml deionized water, each autoclaved (121 °C, 20 min) and cooled down to 60 °C. CaCl2 and Na3PO4 solutions were simultaneously added to solution A under continuous stirring resulting in immediate clouding of the medium through the formation of Ca–P (Ca3(PO4)2) (Eq. 1):
Between 40 and 45 °C, the medium was poured into petri dishes. After solidification and cooling of the agar, suspensions of PGPMs in 2.5 mM CaSO4 (1 × 104 CFU or spores mL−1) were inoculated and plates were incubated at 25 °C. PGPMs included (1) Penicillium sp. PK 112, (2) Pseudomonas sp. DSMZ 13134, (3) Vitalin SP11 [combined product: Bacillus subtilis, Pseudomonas sp., Streptomyces spp., natural humic acids and seaweed extract (Ascophyllum nodosum)] (Vitalin Pflanzengesundheit GmbH, Ober-Ramstadt, Germany), (4), Paenibacillus mucilaginosus (ABiTEP GmbH, Berlin, Germany), (5) Bacillus amyloliquefaciens FZB 42, (6) Trichoderman harzianum T-22.
Additionally, two other media were prepared in which instead of precipitating Ca–P, at 60 °C under continuous stirring, finely ground (< 1 mm Ø) rock phosphate (RP, 7.6% P) or sewage sludge ash (SA, 10.3% P) was added at the rate of 0.3 g P L−1. RP was chosen because it is an important low-cost sparingly soluble inorganic P fertilizer (the only mineral P fertilizer allowed in certified EU organic farming) and SA was selected as a low-cost sparingly soluble recycled P fertilizer produced from sewage treatment. Only Pseudomonas sp. DSMZ 13134 was inoculated on RP and SA solid media because it was one of the best Ca–P solubilizing candidates.
After two days, all petri dishes were observed for clarification of Ca–P, RP or SA along streaks of growing PGPM and scanned on a dark background.
Liquid media culture
Treatments
Based on Deubel-Muromcev solid agar, liquid media with Ca–P was prepared by simply omitting addition of agar to solidify the media. Two other liquid media were prepared in which Ca–P was replaced by either rock phosphate (RP, 7.6%) or sewage sludge ash (SA, 10.3%). For each of these media Ca–P, RP or SA was the only source of P present. The liquid culture conditions, sample collection and preparation, and analysis were based on methods described by [28]. Treatments included factorial combinations of three levels of sparingly soluble P fertilizers (Ca–P, RP or SA) and four PGPM levels as microbial bio-effector (No bio-effector (No BE), Pseudomonas sp. DSMZ 13134 (Pro); Bacillus amyloliquefaciens FZB42 (Rhiz); and Trichoderma harzianum T-22 (T-22). There were four replicates per treatment.
Preparation of solutions
Using sterile deionized water (autoclaved 121 °C, 20 min), 0.2 g K2SO4 and 0.4 g MgSO4·7H2O were dissolved to 1000 mL and pH was adjusted 6.9 (Basal solution); 45.45 g d-glucose was dissolved to 500 mL (glucose); 4 g of l-asparagine was dissolved to 200 mL (l-asparagine); 5.5 g CaCl2·2 H2O was dissolved to 50 mL (CaCl2); 9.5 g Na3PO4·12H2O was dissolved to 50 mL (Na3PO4). 60 mL of Basal solution was transferred into 100-mL Erlenmeyer flasks, autoclaved and then allowed to cool down in a water bath to 80–90 °C. Glucose and l-asparagine were each heated up to 70 °C in a water bath for 30 min. CaCl2 and Na3PO4 were each autoclaved and allowed to cool down to room temperature.
Preparation liquid media
Each P form (Ca–P, RP and SA) was applied separately at the level of each experimental unit (100-mL Schott Duran incubation flask) ensuring 0.018 g P flask−1 because it was impossible to pour out 60 mL portions with the appropriate quantity of P from one stock suspension with sedimenting RP or SA into each 100-mL flask. 1.2 mL CaCl2 and 1.2 mL Na3PO4 were added to 60 ml Basal solution in each flask under continuous stirring to evenly disperse the Ca–P precipitate formed. The total concentration of P was 0.3 g L−1 and NaCl was 1.75 g L−1. 0.237 g RP or 0.174 g SA, each equivalent to 0.018 g P, was weighed with a semi/micro analytical balance (Mettler AT261 DeltaRange, Mettler-Toledo GmbH, Giessen, Germany) and added under continuous stirring to 60 mL Basal solution. The RP and SA used had the following chemical composition: RP, P Total 7.6%; P Citric acid 6.8%; P NaHCO3 1.7%; Al 1.4%; Ca 22.5%; Fe 5.1%; Si 7.7%; SA, P total 10.34%; P citric acid 4.49%; Al 9.9%; Ca 8.6%; Fe 4.2%; Cd 4.2; Cr 90.8; Cu 814; Ni 78.5; Pb 224; V 59.1; Zn 4004 ppm). Total P concentration was also 0.3 g P L−1. 0.105 g of NaCl was added to each RP or SA flask to maintain the same NaCl concentration in Ca–P flasks (1.75 g L−1). In each Ca–P, RP or SA flask, 6.6 mL glucose and 3 mL l-asparagine was added and swelled to mix.
Inoculation and incubation
Using sterile 2.5 mM CaSO4, without PGPM (Control) or with the PGPMs: Pseudomonas sp. DSMZ 13134, 6.6 × 1010 CFUs g−1 (Pro), Bacillus amyloliquefaciens FZB42, 2.5 × 1010 Spores mL−1 (Rhiz) and Trichoderma harzianum T-22, 1 × 109 Spores g−1 (T-22) were each sequentially diluted to produce a suspension of 1 × 104 CFU or spores mL−1. For the non-inoculated control, 2 mL of sterile 2.5 mM CaSO4 solution was added to each flask. For each PGPM treatment, 2 mL inoculum suspension was added. All flasks were randomly placed on two shelves in an incubator (GFL Typ 3032, Gesellschaft für Labortechnik mbH, Burgwedel, Germany) in darkness at 30 °C. To prevent sedimentation of Ca–P, RP or SA, flasks were continuously swelled horizontally at 125 rpm.
Measurements
After 65 h of incubation, 10 mL sample of medium was collected from each flask into a sterile 50-mL falcon tube after solids could settle. Tubes were centrifuged at 5000×g for 15 min and supernatants were carefully poured into 30-mL polyethylene bottles and stored frozen (− 18 °C). For further analysis, samples were defrosted at room temperature, pH was measured (pH/Conductivity Meter, MPC227, Metler Toledo) and they were filtered through P-free blue-band filter papers (MN 640 d) for later analysis of total P concentration by inductively coupled plasma optical emission spectrometry (ICP-OES) (Core Facility Hohenheim, University of Hohenheim).
Acid and alkaline phosphatase activity in the samples was also measured. Phosphatase activity gave an indication of the rate of mineralization or turnover of phosphates that have been assimilated already into organic matter. Phosphatase measurement had no relevance to initial solubilization of inorganic phosphates. Based on a modified p-nitrophenyl phosphate method ([29], phosphatase activity was measured by dephosphorylation of 0.1 mL of 150 mM p-nitrophenyl phosphate in 1.5-mL Eppendorf tube, which contained 0.4 mL buffer (200 mM Na-acetate buffer, pH 5.2 for acid phosphatase or 200 mM Na-borate buffer, pH 8.2 for alkaline phosphatase), 0.4 mL deionized water and 0.1 mL liquid culture supernatant. The mixture was incubated at 30 °C under continuous shaking. For acid phosphatase activity, incubation was stopped after 30 min, whereas for alkaline phosphatase activity, it was stopped after 45 min to ensure a detectable coloration. To stop enzyme activity, 0.5 mL of 0.5 M NaOH was added immediately after incubation. For controls or blanks, a second set of tubes containing liquid media sample and buffer was incubated as described above. After incubation, NaOH was added followed by p-nitrophenyl phosphate. Both sets of samples and blanks were centrifuged (14,000 rpm for 5 min). About 800 µL supernatant was pipetted into a 1 mL disposable micro cuvette and measured for absorbance of yellow coloration at 405 nm usingp-nitrophenol (p-NP) standards containing volumes of p-NP stock (20 µg mL−1), 500 µl 0.5 M NaOH and volumes of deionized water to top up to 1.5 mL. p-NP standards included: 0, 2, 4, 8, 12, 16 and 20 µg p-NP mL−1.
Establishment of Pseudomonas sp. DSMZ13134 rhizosphere hotspots
The methodology for this experiment has been fully described in Nkebiwe et al. [30]. Using a substrate composed of 80% loess [(P CAL, 5 mg kg−1; P total, 332 mg kg−1; pH (CaCl2), 7.6; CaCO3, 23.3%; C org, < 0.3%; N total 0.02%)] and 20% sand filled in rhizoboxes as described in “Effect of background N min on NH4 +-depot root growth” section, maize (Zea mays L. var Colisee) was grown to investigate the establishment of Pseudomonas sp. DSMZ13134 in rhizosphere hotspots around stabilized NH4 +-depots. The substrate was optimally supplied (kg−1 soil DM) with 150 mg P (Ca(H2PO4)2), 150 mg K (K2SO4); 50 mg Mg (MgSO4); 20 µmol Fe, (Sequestrene 138, 6% Fe); 2.6 mg Zn (ZnSO4) and 1 mg Cu, (CuSO4). Moisture content was 18%. 2400 g of substrate was filled into each rizobox (H × W × D: 40 × 20 × 2 cm).
Treatments included two factorial combinations of two N-fertilizer levels and two BE levels. N levels were 100 mg NO3–N kg−1 soil as CaNO3 homogenously mixed in the substrate (NO3 −-mixed) and 100 mg NH4–N as concentrated 15N labelled stabilized (NH4)2SO4 + DMPP (64 mg N mL−1) placed as a depot 5 × 5 cm to the maize seed (NH4 +-depot). BE levels were non-inoculated control (NoBE) and Pseudomonas sp. DSMZ13134 (Pro) inoculated twice by placement at 0 and 23 DAS each at the rate 1 × 109 CFUs kg−1 soil in the area 2.5 cm around the NH4 +-depot or corresponding location for NO3 −-mixed treatments. The 15N-labelled (NH4)2SO4 fertilizer solution was enriched using 15N-(NH4)2SO4 to 10 atom%.
Concentration and contents of shoot N and P, shoot DM, rhizosphere pH, root length density and root colonization of Pseudomonas sp. DSMZ13134 in the NH4 +-depot or corresponding location for NO3 −-Mixed treatments as described already [30]. 15N signal of dried shoot biomass was measure by isotope ratio mass spectrometry (IRMS). During grinding of dried maize shoot samples, some contamination of non-labelled samples with 15N-labelled ones occurred. Nevertheless, this did not prove to be problematic due the big differences in 15N signal between labelled and non-labelled plants because of the very high labeling rate of the placed (NH4)2SO4 + DMPP fertilizer with 15N.
Results
Effect of background N min on NH4 +-depot root growth
At 12 days after planting (DAP), no root growth towards the NH4 +-depot was observed. At 36 DAP, root length (or length per unit surface area) 4 cm around the depot was low, without differences across treatments (Fig. 1a). At 4–8 cm around the depot, root length was lower in soil with no background N fertilization (0 mg N kg−1) than in those with 5, 20 and 60 mg N kg−1. At > 8 cm around the depot, it increased with increasing background N from 0, 5 to 20 mg N kg−1 and then decreased at 60 mg N kg−1. At 56 DAP in the zone > 8 cm around the depot, the same trend could be observed (Fig. 1b). Furthermore, there were no differences in root growth 0–4 cm and 4–8 cm around the depot across treatments at 56 DAP (Figs. 1b, 2). Nevertheless, the trend of increasing root growth in 0–4 or 4–8 cm zones with increasing N min from 0–20 mg N kg−1 followed by a decrease at 60 mg N kg−1 could be observed. However, after washing away soil from the rhizoboxes, intense rooting induced by the NH4 +-depot in soil areas with less toxic NH4 + concentrations could be observed across all background N min levels (Fig. 2).
Root length around the NH4 +-depot at 36 (a) and 56 (b) days after planting. Different letters show significant difference between treatments (P < 0.05) (mean ± SEM, n = 4, One Way ANOVA, Tukey test, α = 0.05). Bold letters: total root length; small letters: root length within radial zones around the depot only if differences were significant. Brown, yellow and green sections of bars represent root growth at radial zones 0–4 cm, 4–8 cm and > 8 cm from the depot, respectively. Numbers within bars represent root length per unit surface area on the rhizobox window (cm cm−2)
As expected, residual NO3–N in the bulk soil increased with increasing background N fertilization from 0 to 60 mg N kg−1, whereas residual NH4–N was low and similar across treatments (Fig. 3a). Within the NH4 +-depot, NO3–N levels were low, whereas NH4–N levels where high, with no differences across treatments (Fig. 3b). Shoot dry matter per rhizobox at background N fertilization of 20 mg N kg−1 (3.7 g) was higher than those of 0 mg N kg−1 (2.9 g) and 5 mg N kg−1 (2.6 g) but not different from that of 60 mg N kg−1 (3.4 g) (n = 4, tukey test, P < 0.05).
Residual N min in the bulk soil (a) and in the NH4 +-depot (b) at 56 DAP. Different letters show significant difference between treatments, if differences were significant (P < 0.05) (mean ± SEM, n = 4, One-Way ANOVA, Tukey test, α = 0.05). Data for bulk soil NH4 +–N and total N min were transformed by square roots. Block letters: difference in total N min concentrations; small letters: difference in NH4 +–N concentrations. Yellow and green section of bars represent NH4 +–N and NO3 −–N concentrations, respectively
PGPM tolerance to high N concentrations
For all strains of Trichoderman harzianum, mycelia diameter showed a tendency to increase with increasing NH4–N concentrations from 0 to 10 mM, followed by a slight decrease at 50 mM. Mycelium diameter at 50 mM NH4–N was higher than the one at 250 mM, which again was higher than the one at 1250 mM (Fig. 4).
After 1 week, there was some growth at 1250 mM NH4–N for all T. harzianum strains meanwhile the typical green centric ring indicating conidia formation at maturity [31] could be seen only in petri dishes with NH4–N levels from 0 to 250 mM NH4–N. Therefore, whereas 250 mM NH4–N depressed vegetative growth only, the toxicity of 1250 mM inhibited both vegetative and generative growth.
Penicillium sp. PK 112 grew slower than Trichoderma. After 1 week the mycelium diameter of Penicillium sp. PK 112 at 10 and 50 mM NH4–N were higher than those at 0 and 2 mM NH4–N. It increased from 2.53 cm at 0 mM NH4–N to 2.93 cm at 50 mM NH4–N (P < 0.05), after which it showed a tendency to decrease to 2.87 cm at 250 mM NH4–N (no significant difference). Atypical and limited growth was observed at 1250 mM NH4–N.
For bacterial PGPMs, considerable growth could be observed at high NH4–N levels after 1 week. For Pseudomonas sp. DSMZ 13134 colonies were circular, yellow, smooth, glistening, entire and convex. The typical yellow pigment which was spread outwards from each colony was intense and distinct only in agar containing 0–250 mM NH4–N. Colonies also showed typical yellow-green fluorescence under UV light. On DEV medium, Bacillus amyloliquefaciens FZB42 formed distinct punctiform colonies with typical spreading bio-films, which were less spread at 250 and 1250 mM NH4–N (Fig. 5). There were more B. amyloliquefaciens FZB42 colonies at 250 mM NH4–N (97) than at 0 mM (59) (P = 0.017). On nutrient agar, colonies of B. amyloliquefaciens FZB42, B. atrophaeus, B. simplex R41 and Bacillus spec. were less distinct and bio-films were also observed across all NH4–N concentrations.
For T. harzianum T-22 after 15-min pre-incubation of mycelium fragment in NH4 + ± DMPP, NH4–N concentration (P = 0.007) and presence of DMPP (P = 0.015) affected mycelium diameter without any interaction between factors (P = 0.575). Irrespective of the presence of DMPP, mycelium diameter at 3 M NH4–N (4.95 cm) was less than the one at 0 M NH4–N (5.54 cm) (P = 0.005); and irrespective of NH4–N level, mycelium diameter with DMPP (5.16 cm) was less than the one without (5.44 cm) (P = 0.015) (Fig. 6). After 15-min pre-incubation in 0 and 0.1 M NH4–N, Pseudomonas sp. DSMZ 13134 and B. amyloliquefaciens FZB42 showed growth activity without any observable effect of DMPP. At 1 and 3 M NH4–N, growth of both Pseudomonas sp. DSMZ 13134 and B. amyloliquefaciens FZB42 was suppressed (more for Pseudomonas sp. DSMZ 13134) and normal morphological colony characteristics were absent. Nevertheless, typical fluorescence under UV light was observed for Pseudomonas sp. DSMZ 13134 as well as typical bio-film formation for B. amyloliquefaciens FZB42 was observed.
Mycelium diameter of Trichoderma harzianum T-22 affected by 15-min pre-incubation in NH4–N solution with DMPP (a) or without (b) or without. Block letters: difference between variants with DMPP and those without (significant effect of DMPP P = 0.015); Significant effect of NH4 + molarity (P = 0.007); small letters: tendency of difference between treatments (P = 0.055) (mean ± SE, n = 4, One* and Two-way ANOVA, Tukey test, α = 0.05)
After 24-h pre-incubation of PGPM in 1 or 3 M·NH4–N solution with or without DMPP, growth of T. harzianum T-22, Pseudomonas sp. DSMZ 13134 or Bacillus amyloliquefaciens FZB42 were strongly suppressed.
Solubilization of inorganic phosphates by PGPMs
All tested PGPMs except T. harzianum T-22 were able to solubilize Ca–P by clarifying the agar along PGPM streaks (Fig. 7a–f). No visible changes could be observed along streaks of Pseudomonas sp. DSMZ 13134 on RP or SA agar (Fig. 7i). Sedimentation of RP or SA at the bottom of the petri dishes (Fig. 7g, h), suggested lack of contact between growing Pseudomonas on the agar surface and RP or SA at the bottom. This implied that liquid media cultures were more appropriate to test the ability of PGPMs to solubilize RP and SA.
PGPMs solubilize/clarify cloudy Ca–P precipitate but not rock phosphate (RP) or sewage sludge ash (SA). Cloudy Ca–P precipitate (Ca3(PO4)2) solubilized and clarified by Penicillium sp. PK 112 (a), Pseudomonas sp. DSMZ 13134 (b), Vitalin SP11 [combined product: Bacillus subtilis, Pseudomonas sp., Streptomyces spp., natural humic acids and seaweed extract (Ascophyllum nodosum)] (c), Paenibacillus mucilaginosus (d), Bacillus amyloliquefaciens FZB 42 (e). But it was not solubilized by Trichoderma harzianum T-22 (f). Growth of Pseudomonas sp. did not lead to any visual changes with RP (g) or SA (h). A piece of agar inverted to show SA sediment (i)
The pH of the media after 65 h varied among and within treatments. In comparison to the starting pH, there was a reduction in the pH of the nutrient medium in the following treatments: Ca–P/Pro, RP, RP/Pro, RP/Rhiz, SA, SA/Pro, SA/Rhiz and SA/T-22 (Fig. 8a). The concentration of P in liquid media (P conc.) was decreasing in the following order: Ca–P/Pro, RP/Pro, RP/Rhiz, RP/T-22 and RP. Very low P conc. were measured in the other treatments (Fig. 8b). For all treatments, pH showed a significant negative correlation with P conc. (P = 0.002; r = − 0.47).
Change in pH (a), total P concentration (b), acid- (c) and alkaline phosphatase activity (d) in the liquid fraction of media 65 h after onset of incubation. Ca–P, Ca3(PO4)2; RP, rock phosphate; SA, sewage sludge ash; Pro, Pseudomonas sp. DSMZ 13134; Rhiz, Bacillus amyloliquefaciens FZB42; T-22, Trichoderma harzianum T-22. pH was inversely correlated to total P concentration (P = 0.002; r = − 0.47)
Increase in microbial biomass could be observed by the cloudy or murky appearance of the media for Pro and Rhiz variants and a thick mesh of mycelium for T-22 variants.
There was also much variability in acid and alkaline phosphatase activity (P ase) among and within treatments (Fig. 8c, d). pH or P conc. did not correlate with acid or alkaline phosphatase activity.
Establishment of Pseudomonas sp. DSMZ13134 rhizosphere hotspots
Placement of 15N-labelled stabilized (NH4)2SO4 + DMPP had an effect on root length density (RLD), and rhizosphere pH 5 × 5 cm to seeds, shoot 15N signal and shoot N and P concentrations and contents at 55DAS. Inoculation of Pseudomonas sp. DSMZ13134 had an effect on shoot 15N signal and shoot N concentrations (Table 2) at 55DAS.
A higher number of CFUs of fluorescent Pseudomonads could be recovered from root rhizoplane per unit soil volume within the zone 5 × 5 cm to seed (8 cm radius) in the NH4 +-Depot treatment (13.01 Log10 CFUs cm−3 soil) than in the corresponding zone in NO3 −-mixed treatment (12.38 Log10 CFUs cm−3 soil) (t test α = 0.05, P = 0.045) [30].
Discussion
Root growth in the centre NH4 +-depot was strongly inhibited because of the presence of highly phytotoxic concentrations of NH4 +, as confirmed by N min analysis of depot soil samples. During the growth period, root length increased in all radial zones around the NH4 +-depot. During early growth stages, root length in all zones towards the depot increased with increasing background N min from 0 to 20 mg N kg−1 only. This was likely due to low background N min levels during early growth stages, N supply to shallow root systems was inadequate for optimal root growth towards the depot. Localized root growth around the depot increased at later growth stages when the expanding N-rich boarder areas of the NH4 +-depot became accessible to plants roots. This suggests that to optimally supply plants with N especially during early growth stages, it is effective to place starter N fertilizer close to seeds (about 5 cm below) to ensure rapid roots access [4]. However, in case of considerable nutrient mobility from depot to seeds, it is advisable to place starter N farther from seeds to avoid harmful osmotic effects and ion toxicity [32]. At 56 DAP, differences in root length occurred only in the zone > 8 cm, in which root growth was also most intense. Increasing root length in all radial zones around the depot with time and with increasing background N min from 0 to 20 mg N kg−1 suggests that moderate N availability in the bulk soil favoured initial root growth and subsequent root growth intensification around the NH4 +-depot. Given very high NH4–N levels in the depot, the high background N level of 60 mg N kg−1 may have led to N toxicity effects resulting in reduced overall root and shoot growth.
Although background N fertilization was with an NH4–N share of 50%, only traces of NH4–N could be measured in the bulk soil after 56 days. This showed that rapid nitrification of NH4–N applied in the bulk soil occurred, resulting in residual N min with an NH4–N share of only 2.4% (60 mg N kg−1) to 11.9% (5 mg N kg−1). This can be partially explained by the absence of a nitrification inhibitor (NI) in the NH4NO3 used for bulk soil N fertilization. However, in soil without background N fertilization (0 mg N kg−1), low N min levels (2.8 mg NO3–N kg−1 and 0.87 mg NH4–N kg−1) could be measured in the bulk soil with a low NH4–N share of 23.7%, suggesting diffusion of N from the depot into the bulk soil as NH4 + as well as NO3 − after nitrification. In the treatments 5, 10, 20 and 60 mg N kg−1, bulk soil NH4–N concentrations were similar to the one in the treatment without background N fertilization (0 mg N kg−1) after the growth period. This confirmed that bulk soil NH4 + at the end of the growth period partially originated from the stabilized NH4 +-depot directly by diffusion. Given the small substrate volume of the depot, the low clay and organic matter content of the loess-dominated substrate, the high substrate moisture content and high quantity of NH4 + that was placed, NH4 + probably diffused out of the initial depot boarders after sites for NH4 +-fixation were exhausted. This is supported by the zones around the initial depot boarders with little or no root growth likely due to the presence of phytotoxic NH4 + levels. This is further proven by the strong decrease in the NH4–N concentration within the depot from the estimated rate of 78.4 mg g−1 soil [estimated placement rate 1 g NH4 +–N to 5 cm3 depot soil volume (2.5 cm Ø × 2 cm depth, bulk density, 1.3 g cm−3)] at the start of the experiment to the measured concentration of 0.18 mg NH4–N g−1 after 56 days.
Despite considerable diffusion of NH4 + from the depot into the bulk soil during the experiment, low residual NH4 + concentrations measured in the bulk soil after 56 days may be explained by nitrification after diffusion of NH4 + out of the phytotoxic zones surrounding the depot resulting. With NO3 −-formation, the N-diffusion rate is expected to be more rapid that with NH4 + [4, 6]. High residual NH4 + concentrations in the depot (0.18 mg NH4–N g−1) at the end of the growth period showed that high concentrations of (NH4)2SO4 + DMPP in a subsoil depot inhibits biological nitrification of the placed NH4 + by both toxicity effects of high NH4 + concentrations and the presence of DMPP [11, 12, 33]. This enabled placed N to persist in the depot zone as root growth stimulating and root-attracting NH4 +. Therefore, intense localized root growth could be observed around a subsurface fertilizer depot based on high concentrations of NH4 + stabilized with DMPP, which led to higher N and P concentrations and contents in maize shoots (Zea mays L.) in comparison to variants with homogenously incorporated NO3 −-fertilizer [30].
This study also showed that soil zones around NH4 +-depots with high root densities may be sites for effective root colonization by inoculated PGPMs. Nevertheless, in addition to cultures on selective media, molecular tracing techniques like qPCR [34] as already shown for Pseudomonas sp. DSMZ 13134 would provide more precision in tracing. In densely rooted soil, the establishment of PGPMs may have been promoted by high levels of root exudates that boost growth and activity of rhizosphere dwelling microorganisms [15, 35,36,37].
All tested fungal and bacterial PGPMs showed normal or improved growth activity on solid nutrient agar containing as high as 50 mM NH4–N and slightly inhibited growth at 250 mM H4–N except for B. amyloliquefaciens FZB42 and Penicillium sp. PK 112. In contrast to plant and animal cells, bacteria preferentially use NH4 + as a source of N and can be tolerant even to molar concentrations of NH4–N, at which point growth limiting effects may be related more to osmotic or ionic imbalances than to direct toxic effects of NH4 + ions per se [38]. The threshold concentration range of 50–250 mM NH4–N at which cultured PGPMs showed that inhibited growth is above the range for NH4 + toxicity in sensitive crop species like barley (Hordeum vulgare L.) and tolerant ones like rice (Oryza sativa L.) grown hydroponically [39,40,41]. The NH4 + tolerance threshold for our tested PGPMs (50–250 mM NH4–N) is also above the range of 2–20 mM that can be common in soil solution of most agricultural soils [42]. The range is also above the NH4–N concentrations that can be measured in soil solution a few centimeters from a subsurface NH4 +-fertilizer band (extracted by centrifuging soil samples collected a few centimeters from a subsurface NH4 +-fertilizer band (< 0.001–37 mM NH4–N and 0.4–91 mM NH4–N from a distance 4–2 cm to a fertilizer band of (NH4)2S04) and di-ammonium phosphate, respectively, after 5 days of contact of bands with soil, for tests on five different soil types) [43, 44].
Furthermore, all tested PGPMs showed limited growth activity at the very high NH4–N level of 1250 mM, which could be explained by osmotic and ionic imbalances as proposed earlier. After 15-min pre-incubation of inoculum suspended in 0–3 M NH4–N, growth of T. harzianum T-22 was slightly inhibited in the presence of DMPP meanwhile for Pseudomonas sp. DSMZ 13134 and B. amyloliquefaciens FZB42 after pre-incubation in 0–0.1 M NH4–N, growth activity was not affected by DMPP. After 24-h pre-incubation in 1–3 M NH4–N solution with or without DMPP, normal growth activity of PGPMs on solid media could no longer be achieved. This suggests that PGPMs may not be applied directly into a concentrated NH4 +-fertilizer solution (> 50 mM NH4–N). Alternatively, PGPMs should be inoculated in soil zones with lower NH4–N levels in the border regions of a concentrated toxic ammonium [30] or directly into the NH4 +-fertilizer solution if it is less concentrated.
The classical test for P solubilization on solid Ca–P media confirmed that all the tested PGPMs except Trichoderman harzianum T-22 were capable to solubilize inorganic P. On solid media culture, Pseudomonas sp. DSMZ 13134 effectively solubilized Ca–P, whereas it led to no observable changes after growth on agar with rock phosphate (RP) or sewage sludge ash (SA). However, in liquid media cultures, Pseudomonas sp. DSMZ 13134, Bacillus amyloliquefaciens FZB42 and Trichoderma harzianum T-22 solubilized RP more than SA. Best performing PGPMs were Pseudomonas sp. DSMZ 13134 and B. amyloliquefaciens FZB42. Increase in microbial biomass, especially for T. harzianum T-22, suggested that the P concentrations measured in cell-free culture-media filtrates represented underestimations of the P-solubilizing potential of tested PGPMs because measured P concentrations did not account for solubilized P that was subsequently immobilized in microbial biomass of T. harzianum T-22 [20]. Inoculation of T-22 did not result in considerable acidification of the Ca–P medium. Similarly to the results described by [20] (2 µg P mL−1 at pH 5, 48 h incubation of medium containing 0.16 g RP–P L−1), inoculation of T-22 resulted in acidification of the RP medium, however, it did not lead to high P concentrations in media filtrates (35.7 µg P mL−1 at pH 5.7–7.4, 65 h incubation containing 0.3 g RP–P L−1). This can also be explained by immobilization of solubilized P in the dense T-22 mycelium that was observed. Low pH values were measured in SA media with or without inoculated PGPM which corresponded to low P concentrations in media filtrates. In addition to immobilization of solubilized P in microbial biomass, low P concentrations in SA medium despite low medium pH may be explained by fixation of PO4 3− by Al3+ and Fe3+ which may be available at low pH conditions given the high SA concentrations of Al (9.9%, 0.29 g SA–Al L−1) and Fe (4.2%, 0.12 g SA–Fe L−1). This explanation supports the observation that P concentrations increased with decreasing pH in the RP medium because RP had a much lower concentrations of Al (1.4%, 0.06 g RP–Al L−1) and about the same concentration of Fe (5.1%, 0.20 g RP–Fe L−1) as the SA medium. We recorded pH values as low as 3.7 in cell-free filtrates of culture media inoculated with Pseudomonas sp. DSMZ 13134 or B. amyloliquefaciens FZB42. This suggested that acidification by release of protons and/or low-molecular weight organic acids as already reported [20] ([24, 45,46,47] may have been the likely mode of action for the solubilization of the inorganic P forms. This argument is supported by the significant negative correlation between pH and P concentration in the media (P = 0.002; r = − 0.47). For liquid media with RP only, the correlation was even stronger (P < 0.0001; r = − 0.84). Similarly to pH and total P concentration, there was high variability in acid and alkaline phosphatase activity within and between treatments. Measured acid and alkaline phosphatase activities may only be regarded as an indicator of the turnover or mineralization of organic P [21] and not as a marker for solubilization of inorganic P. For the RP medium, there was a positive correlation between P concentration and phosphatase activity (P = 0.015; r = − 0.77) indicating some turnover of organic P. Nevertheless, solubilization of inorganic P by various PGPMs in in vitro cultures does not guarantee improved P acquisition and yield of plants in soil systems containing inorganic P and inoculated with a P-solubilizing PGPM [47]. Results of in vitro Ca–P solubilization tests as a way to assess P-solubilizing potential of PGPMs and their potential to improve crop P acquisition must be critically evaluated for each soil type, and their chemical and physical properties [21]. For instance, it has been shown that maize P acquisition and biomass production after inoculation of PGPM in was strongly dependent on soil type and properties such as pH and overall fertility [48]. To increase the likelihood for identifying P-solubilizing PGPMs that are effective under field conditions, it is suggested to use the right in vitro test for PGPMs isolated from the right soil type: Ca–P or RP solubilization test for PGPMs isolated from alkaline soils; Fe–P/Al–P solubilization with PGPMs from acid soils; and phytate mineralization with those from soils rich in organic matter [21].
Several mechanisms for PGPMs to directly or indirectly improve acquisition of soil or fertilizer nutrients by crop plants such as root growth stimulation, nutrient solubilization and mineralization, and induction of resistance to biotic and abiotic stresses have been clearly described already [14,15,16, 18,19,20, 22, 25, 35, 49].
Sometimes, promised beneficial effects of several commercially available PGPMs are not realized even in controlled greenhouse conditions [50] or in the field [15]. This may be explained by rapid decline in PGPM populations often observed after inoculation in natural soil due to competition for nutrients, predation by other soil organisms or other unfavourable biotic or abiotic factors [37].
In our rhizobox experiment, placement of 15N-labelled stabilized (NH4)2SO4 + DMPP as a depot led to the formation of intense localized root growth around the depot (rhizosphere hotspot), which in turn led to improved N-uptake as shown by higher shoot N concentration, 15N signal and N content compared to plants under homogenous supply of NO3 −. Placement of the NH4 +-depot also led to rhizosphere acidification, which coupled with dense localized root growth led to higher shoot P concentration and content than in plants under homogenous supply of NO3 −. Inoculation of Pseudomonas sp. DSMZ13134 in soil zones in which rhizosphere hotspots developed in response to placed root-attracting NH4 +-depots promoted the establishment of fluorescent Pseudomonas [30]. Inoculation of Pseudomonas sp. DSMZ13134 showed a trend to improve shoot N concentration and content and shoot P concentration when compare to the non-inoculated control.
Improved rhizosphere colonization of maize roots (Zea mays L.) around an NH4 +-depot by rifampicin-resistant Bacillus amyloliquefaciens FZB42 has also been observed in a pot experiment (Mohammad et al. 2016, unpublished master thesis, Nutritional Crop Physiology, University of Hohenheim).
In addition to inoculating PGPMs in NH4 +-based rhizosphere hotspots, inoculation of PGPM strains that are adapted or compatible to specific soil properties [21, 51], utilization of suitable nutrient additives, carrier materials and inoculation techniques may increase their survival rates PGPMs after inoculation in soil [37, 52].
Conclusions
Placement of a highly concentrated subsurface NH4 +-depot induced the formation of rhizosphere hotspots with intense rooting around the depots with moderate bulk soil N min favouring depot-zone root growth. PGPMs that readily solubilized sparingly soluble inorganic P showed considerable tolerance to high NH4 + concentrations. Among these NH4 +-tolerant PGPMs, rhizosphere hotspot establishment of Pseudomonas sp. DSMZ13134 was tested and found to be promoted the NH4 +-depots in rhizobox-grown maize (Zea mays L.) in comparison to corresponding soil zones under homogenous supply of NO3 −. N-form effects on shoot N and P concentration and content were stronger than that of PGPM.
Abbreviations
- 14NO3 −-mixed:
-
non-isotopically labelled Ca(NO3)2 homogenously mixed in substrate
- 15NH4 +-depot:
-
15N-labelled stabilized (NH4)2SO4 + DMPP placed as a depot
- BE:
-
bio-effector
- Ca–P:
-
tri-calcium phosphate (Ca3(PO4)2)
- CULTAN:
-
controlled long-term ammonium nutrition
- DAP:
-
days after planting
- DMPP:
-
nitrification inhibitor 3,4-dimethylpyrazole phosphate
- ICP-OES:
-
inductively coupled plasma optical emission spectrometry
- IRMS:
-
isotope ratio mass spectrometry
- NoBE:
-
no bio-effector
- PGPM:
-
plant growth-promoting microorganism
- Pro:
-
Pseudomonas sp. DSMZ 13134
- Rhiz:
-
Bacillus amyloliquefaciens FZB42
- RLD:
-
root length density
- RP:
-
rock phosphate
- SA:
-
sewage sludge ash
- T-22:
-
Trichoderma harzianum T-22
References
Federolf C, Westerschulte M, Olfs H, Broll G, Trautz D. Enhanced nutrient use efficiencies from liquid manure by positioned injection in maize cropping in northwest Germany. Eur J Agron. 2016;75:130–8.
Jing J, Zhang F, Rengel Z, Shen J. Localized fertilization with P plus N elicits an ammonium-dependent enhancement of maize root growth and nutrient uptake. Field Crop Res. 2012;133:176–85.
Miller MH, Ohlrogge AJ. Principles of nutrient uptake from fertilizer bands 1. Effect of placement of nitrogen fertilizer on the uptake of band-placed phosphorus at different soil phosphorus levels1. Agron J. 1958;50(2):95–7.
Nkebiwe PM, Weinmann M, Bar-Tal A, Müller T. Fertilizer placement to improve crop nutrient acquisition and yield: a review and meta-analysis. Field Crop Res. 2016;196:389–401.
Drew MC. Comparison of the effects of a localised supply of phosphate, nitrate, ammonium and potassium on the growth of the seminal root system, and the shoot, in barley. New Phytol. 1975;75(3):479–90.
Barber SA. Soil nutrient bioavailability: a mechanistic approach. New York: Wiley; 1984.
Schenk MK, Barber SA. Phosphate uptake by corn as affected by soil characteristics and root morphology. Soil Sci Soc Am J. 1979;43(5):880–3.
Clarke AL, Barley KP. The uptake of nitrogen from soils in relation to solute diffusion. Aust J Soil Res. 1968;6(1):75–92.
Pang PC, Hedlin RA, Cho CM. Transformation and movement of band-applied urea, ammonium sulfate, and ammonium hydroxide during incubation in several Manitoba soils. Can J Soil Sci. 1973;53(3):331–41.
Lamb EG, Haag JJ, Cahill JF. Patch–background contrast and patch density have limited effects on root proliferation and plant performance in Abutilon theophrasti. Funct Ecol. 2004;18(6):836–43.
Sommer K. CULTAN-Düngung: physiologisch, ökologisch, ökonomisch optimiertes Düngungsverfahren für Ackerkulturen, Grünland, Gemüse, Zierpflanzen und Obstgehölze. Germany: Verlag Th. Mann; 2005.
Zerulla W, Barth T, Dressel J, Erhardt K, Horchler von Locquenghien K, Pasda G, Rädle M, Wissemeier A. 3,4-Dimethylpyrazole phosphate (DMPP)—a new nitrification inhibitor for agriculture and horticulture. Biol Fertil Soils. 2001;34(2):79–84.
Gross KL, Peters A, Pregitzer KS. Fine root growth and demographic responses to nutrient patches in four old-field plant species. Oecologia. 1993;95(1):61–4.
Jiang Y, Wu Y, Xu W, Cheng Y, Chen J, Xu L, Hu F, Li H. IAA-producing bacteria and bacterial-feeding nematodes promote Arabidopsis thaliana root growth in natural soil. Eur J Soil Biol. 2012;52:20–6.
Lugtenberg B, Kamilova F. Plant-growth-promoting rhizobacteria. Annu Rev Microbiol. 2009;63(1):541–56.
Mohite B. Isolation and characterization of indole acetic acid (IAA) producing bacteria from rhizospheric soil and its effect on plant growth. J Soil Sci Plant Nutr. 2013;13:638–49.
Shakir MA, Bano A, Arshad M. PGPR with ACC deaminase confer drought tolerance wheat. Soil Environ. 2012;31(1):108–12.
Mavrodi OV, Walter N, Elateek S, Taylor CG, Okubara PA. Suppression of Rhizoctonia and Pythium root rot of wheat by new strains of Pseudomonas. Biol Control. 2012;62(2):93–102.
Vassilev N, Vassileva M, Nikolaeva I. Simultaneous P-solubilizing and biocontrol activity of microorganisms: potentials and future trends. Appl Microbiol Biotechnol. 2006;71(2):137–44.
Altomare C, Norvell WA, Björkman T, Harman GE. Solubilization of phosphates and micronutrients by the plant-growth-promoting and biocontrol fungus Trichoderma harzianum Rifai 1295-22. Appl Environ Microbiol. 1999;65(7):2926–33.
Bashan Y, Kamnev AA, de-Bashan LE. Tricalcium phosphate is inappropriate as a universal selection factor for isolating and testing phosphate-solubilizing bacteria that enhance plant growth: a proposal for an alternative procedure. Biol Fertil Soils. 2013;49(4):465–79.
Barea JM, Toro M, Orozco MO, Campos E, Azcon R. The application of isotopic (32P and 15N) dilution techniques to evaluate the interactive effect of phosphate-solubilizing rhizobacteria, mycorrhizal fungi and Rhizobium to improve the agronomic efficiency of rock phosphate for legume crops. Nutr Cycl Agroecosyst. 2002;63:35–42.
Panda B, Rahman H, Panda J. Phosphate solubilizing bacteria from the acidic soils of Eastern Himalayan region and their antagonistic effect on fungal pathogens. Rhizosphere. 2016. https://doi.org/10.1016/j.rhisph.2016.08.001.
Pérez E, Sulbarán M, Ball MM, Yarzábal LA. Isolation and characterization of mineral phosphate-solubilizing bacteria naturally colonizing a limonitic crust in the south-eastern Venezuelan region. Soil Biol Biochem. 2007;39(11):2905–14.
Singh B, Satyanarayana T. Plant growth promotion by phytases and phytase-producing microbes due to amelioration in phosphorus availability. In: Satyanarayana T, Johri NB, editors. Microorganisms in sustainable agriculture and biotechnology. Dordrecht: Springer Netherlands; 2012. p. 3–15.
Deubel A. Einfluß wurzelbürtiger organischer Kohlenstoffverbindungen auf Wachstum und Phosphatmobilisierungsleistung verschiedener Rhizosphärenbakterien. Dissertation, Martin-Luther-Universität, Halle-Wittenberg, Germany; 1996.
Muromcev GS. Die lösende Wirkung einiger Wurzel-und Bodenmikroorganismen auf die wasserunlöslichen Kalziumphosphate (russ.). Agrobiologija. 1958;5:31–6.
de Freitas JR, Banerjee MR, Germida JJ. Phosphate-solubilizing rhizobacteria enhance the growth and yield but not phosphorus uptake of canola (Brassica napus L.). Biol Fertil Soils. 1997;24(4):358–64.
Tabatabai MA, Bremner JM. Use of p-nitrophenyl phosphate for assay of soil phosphatase activity. Soil Biol Biochem. 1969;1(4):301–7.
Nkebiwe PM, Weinmann M, Müller T. Improving fertilizer-depot exploitation and maize growth by inoculation with plant growth-promoting bacteria: from lab to field. Chem Biol Technol Agric. 2016;3(1):1–16.
Mendoza JLH, Pérez MIS, Prieto JMG, Velásquez JDQ, Olivares JGG, Langarica HRG. Antibiosis of Trichoderma spp strains native to northeastern Mexico against the pathogenic fungus Macrophomina phaseolina. Braz J Microbiol. 2015;46:1093–101.
Niehues BJ, Lamond RE, Godsey CB, Olsen CJ. Starter nitrogen fertilizer management for continuous no-till corn production contribution no. 04-099-j, k-state research and extension. Agron J. 2004;96(5):1412–8.
Shaviv A. Control of nitrification rate by increasing ammonium concentration. Fert Res. 1988;17(2):177–88.
Mosimann C, Oberhänsli T, Ziegler D, Nassal D, Kandeler E, Boller T, Mäder P, Thonar C. Tracing of two Pseudomonas strains in the root and rhizoplane of maize, as related to their plant growth-promoting effect in contrasting soils. Front Microbiol. 2016;7:2150.
Bonkowski M, Cheng W, Griffiths BS, Alphei J, Scheu S. Microbial-faunal interactions in the rhizosphere and effects on plant growth. Eur J Soil Biol. 2000;36:135–47.
van Overbeek LS, van Elsas JD. Root exudate-induced promoter activity in Pseudomonas fluorescens mutants in the wheat rhizosphere. Appl Environ Microbiol. 1995;61(3):890–8.
van Veen JA, van Overbeek LS, van Elsas JD. Fate and activity of microorganisms introduced into soil. Microbiol Mol Biol Rev. 1997;61(2):121–35.
Müller T, Walter B, Wirtz A, Burkovski A. Ammonium toxicity in bacteria. Curr Microbiol. 2006;52(5):400–6.
Coskun D, Britto DT, Li M, Becker A, Kronzucker HJ. Rapid ammonia gas transport accounts for futile transmembrane cycling under NH3/NH4+ toxicity in plant roots. Plant Physiol. 2013;163(4):1859–67.
Chen G, Guo S, Kronzucker HJ, Shi W. Nitrogen use efficiency (NUE) in rice links to NH4+ toxicity and futile NH4+ cycling in roots. Plant Soil. 2013;369(1):351–63.
Esteban R, Ariz I, Cruz C, Moran JF. Review: mechanisms of ammonium toxicity and the quest for tolerance. Plant Sci. 2016;248:92–101.
Britto DT, Kronzucker HJ. NH4+ toxicity in higher plants: a critical review. J Plant Physiol. 2002;159(6):567–84.
Moody PW, Aitken RL, Yo SA, Edwards DG, Bell LC. Effect of banded fertilizers on soil solution composition and short-term root-growth. 1. Ammonium-sulfate, ammonium-nitrate, potassium-nitrate and calcium nitrate. Soil Res. 1995;33(4):673–87.
Moody PW, Edwards DG, Bell LC. Effect of banded fertilizers on soil solution composition and short-term root-growth. 2. Mono-ammonium and di-ammonium phosphates. Soil Res. 1995;33(4):689–707.
Cunningham JE, Kuiack C. Production of citric and oxalic acids and solubilization of calcium phosphate by Penicillium bilaii. Appl Environ Microbiol. 1992;58(5):1451–8.
Goldstein AH. Recent progress in understanding the molecular genetics and biochemistry of calcium phosphate solubilization by Gram negative bacteria. Biol Agric Hortic. 1995;12(2):185–93.
García-López AM, Avilés M, Delgado A. Effect of various microorganisms on phosphorus uptake from insoluble Ca–phosphates by cucumber plants. J Plant Nutr Soil Sci. 2016;179(4):454–65.
Thonar C, Lekfeldt JDS, Cozzolino V, Kundel D, Kulhánek M, Mosimann C, Neumann G, Piccolo A, Rex M, Symanczik S, Walder F, Weinmann M, de Neergaard A, Mäder P. Potential of three microbial bio-effectors to promote maize growth and nutrient acquisition from alternative phosphorous fertilizers in contrasting soils. Chem Biol Technol Agric. 2017;4(1):7.
Richardson A, Barea J, McNeill A, Prigent-Combaret C. Acquisition of phosphorus and nitrogen in the rhizosphere and plant growth promotion by microorganisms. Plant Soil. 2009;321(1–2):305–39.
Schenck zu Schweinsberg-Mickan M, Müller T. Impact of effective microorganisms and other biofertilizers on soil microbial characteristics, organic-matter decomposition, and plant growth. J Plant Nutr Soil Sci. 2009;172(5):704–12.
Zahir ZA, Ghani U, Naveed M, Nadeem SM, Asghar HN. Comparative effectiveness of Pseudomonas and Serratia sp. containing ACC-deaminase for improving growth and yield of wheat (Triticum aestivum L.) under salt-stressed conditions. Arch Microbiol. 2009;191(5):415–24.
Marschner P. Rhizosphere biology. In: Marschner P, editor. Marschner’s mineral nutrition of higher plants. 3rd ed. Academic Press: United States of America; 2012. p. 369–88.
Authors’ contributions
PMN participated in conceiving and designing all studies, ran and managed all experiments, conducted all laboratory analyses (except: soil N min, P concentration by ICP-OES and 15N signal by IRMS), performed statistical analyses and interpretation results, drafted and participated in reviewing the manuscript, agrees to accountability. GN and TM participated in conceiving and designing all studies, participated in interpretation of results, participated in reviewing the manuscript, agree to accountability. All authors read and approved the final manuscript.
Acknowledgements
We would like to express our sincere gratitude for the reliable support provided by the technical staff and student assistants of Fertilization and Soil Matter Dynamics (340 i), University of Hohenheim, Stuttgart, Germany.
Competing interests
The authors declare that they have no competing interests.
Availability of data and materials
Additional data may be available on request to the authors, please contact corresponding author.
Ethics approval and consent to participate
The authors declare that this study does not involve human subjects, human material and human data.
Funding
This study was part of the BIOFECTOR project funded by the European Commission within the 7th Framework Program|Grant Agmt. No. 312117.
Publisher’s Note
Springer Nature remains neutral with regard to jurisdictional claims in published maps and institutional affiliations.
Author information
Authors and Affiliations
Corresponding author
Rights and permissions
Open Access This article is distributed under the terms of the Creative Commons Attribution 4.0 International License (http://creativecommons.org/licenses/by/4.0/), which permits unrestricted use, distribution, and reproduction in any medium, provided you give appropriate credit to the original author(s) and the source, provide a link to the Creative Commons license, and indicate if changes were made. The Creative Commons Public Domain Dedication waiver (http://creativecommons.org/publicdomain/zero/1.0/) applies to the data made available in this article, unless otherwise stated.
About this article
Cite this article
Nkebiwe, P.M., Neumann, G. & Müller, T. Densely rooted rhizosphere hotspots induced around subsurface NH4 +-fertilizer depots: a home for soil PGPMs?. Chem. Biol. Technol. Agric. 4, 29 (2017). https://doi.org/10.1186/s40538-017-0111-y
Received:
Accepted:
Published:
DOI: https://doi.org/10.1186/s40538-017-0111-y